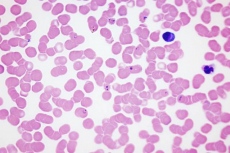

Medicina
Dispositivos energizados vía WiFi y además con conectividad potencial a internet
La recarga inalámbrica automática de pequeños dispositivos eléctricos es una forma cómoda de mantenerlos abastecidos de la energía que necesitan sin necesidad de tener que conectarlos y desconectarlos a un enchufe a través de su cargador. Dejar que el teléfono móvil se recargue solo, desde el bolsillo de la chaqueta colgada en una silla o desde cualquier sitio donde lo hayamos dejado al llegar a casa, podría incluso ser más fácil de lo que se ha venido asumiendo si prospera un nuevo sistema que prescinde de complejas instalaciones de transmisión inalámbrica de energía y en vez de ello aprovecha la energía de las ondas WiFi, tan comunes en muchos sitios. E incluso sería viable energizar directamente pequeños dispositivos, sin que necesitasen llevar baterías, y hasta dotarlos de conectividad a internet.
Shyam Gollakota, de la Universidad de Washington en la ciudad estadounidense de Seattle, y sus colaboradores, son los creadores de este nuevo sistema de comunicación que utiliza esas señales de radiofrecuencia como fuente de energía. Llamada retrodispersión WiFi, esta tecnología es la primera que puede conectar dispositivos sin pilas a la infraestructura WiFi, con una serie de prestaciones extra.
Este innovación se basa en investigaciones previas que mostraron cómo dispositivos de muy bajo consumo, como sensores de temperatura o dispositivos integrados a prendas de vestir, podían funcionar sin pilas ni cables de alimentación eléctrica, aprovechando la energía de las señales de comunicación inalámbrica, incluyendo radio y televisión, ya presentes en el aire. Esta nueva tecnología va un paso más allá, ya que además de lo citado permite conectar cada dispositivo a internet, algo que antes no era posible. Un sistema de este tipo reutiliza la infraestructura WiFi existente para proporcionar conectividad a internet a estos dispositivos, convenientemente preparados, y sin necesitar llevar pilas eléctricas.
![[Img #22036]](upload/img/periodico/img_22036.jpg)
La retrodispersión WiFi utiliza señales de radiofrecuencia como fuente de energía y reutiliza la infraestructura WiFi existente para proporcionar conectividad a internet a dispositivos que no dependen de cables o pilas eléctricas. (Imagen: Universidad de Washington)
En este último aspecto, y teniendo en cuenta que el acceso a internet brindado por esta tecnología implica un abaratamiento considerable de costos y de requerimientos energéticos para el acceso vía WiFi, quizá estemos ante un primer paso sólido hacia el concepto que se ha dado en definir como "la Internet de las Cosas". Este consiste, a grandes rasgos, en una facilidad tan grande de acceso vía WiFi a internet que casi cualquier objeto podría tenerlo, desde una nevera a un bolígrafo, por ejemplo. El resultado sería extender la conectividad a quizás miles de millones de dispositivos. Sin embargo, esto sería de especial utilidad para dispositivos como por ejemplo sensores, sin pilas eléctricas, que estarían alojados dentro de objetos cotidianos para ayudar a controlar y monitorizar multitud de cosas que van desde la seguridad estructural de puentes hasta la salud del corazón.
El equipo de investigación planea poner en marcha una empresa dedicada a esta nueva tecnología.